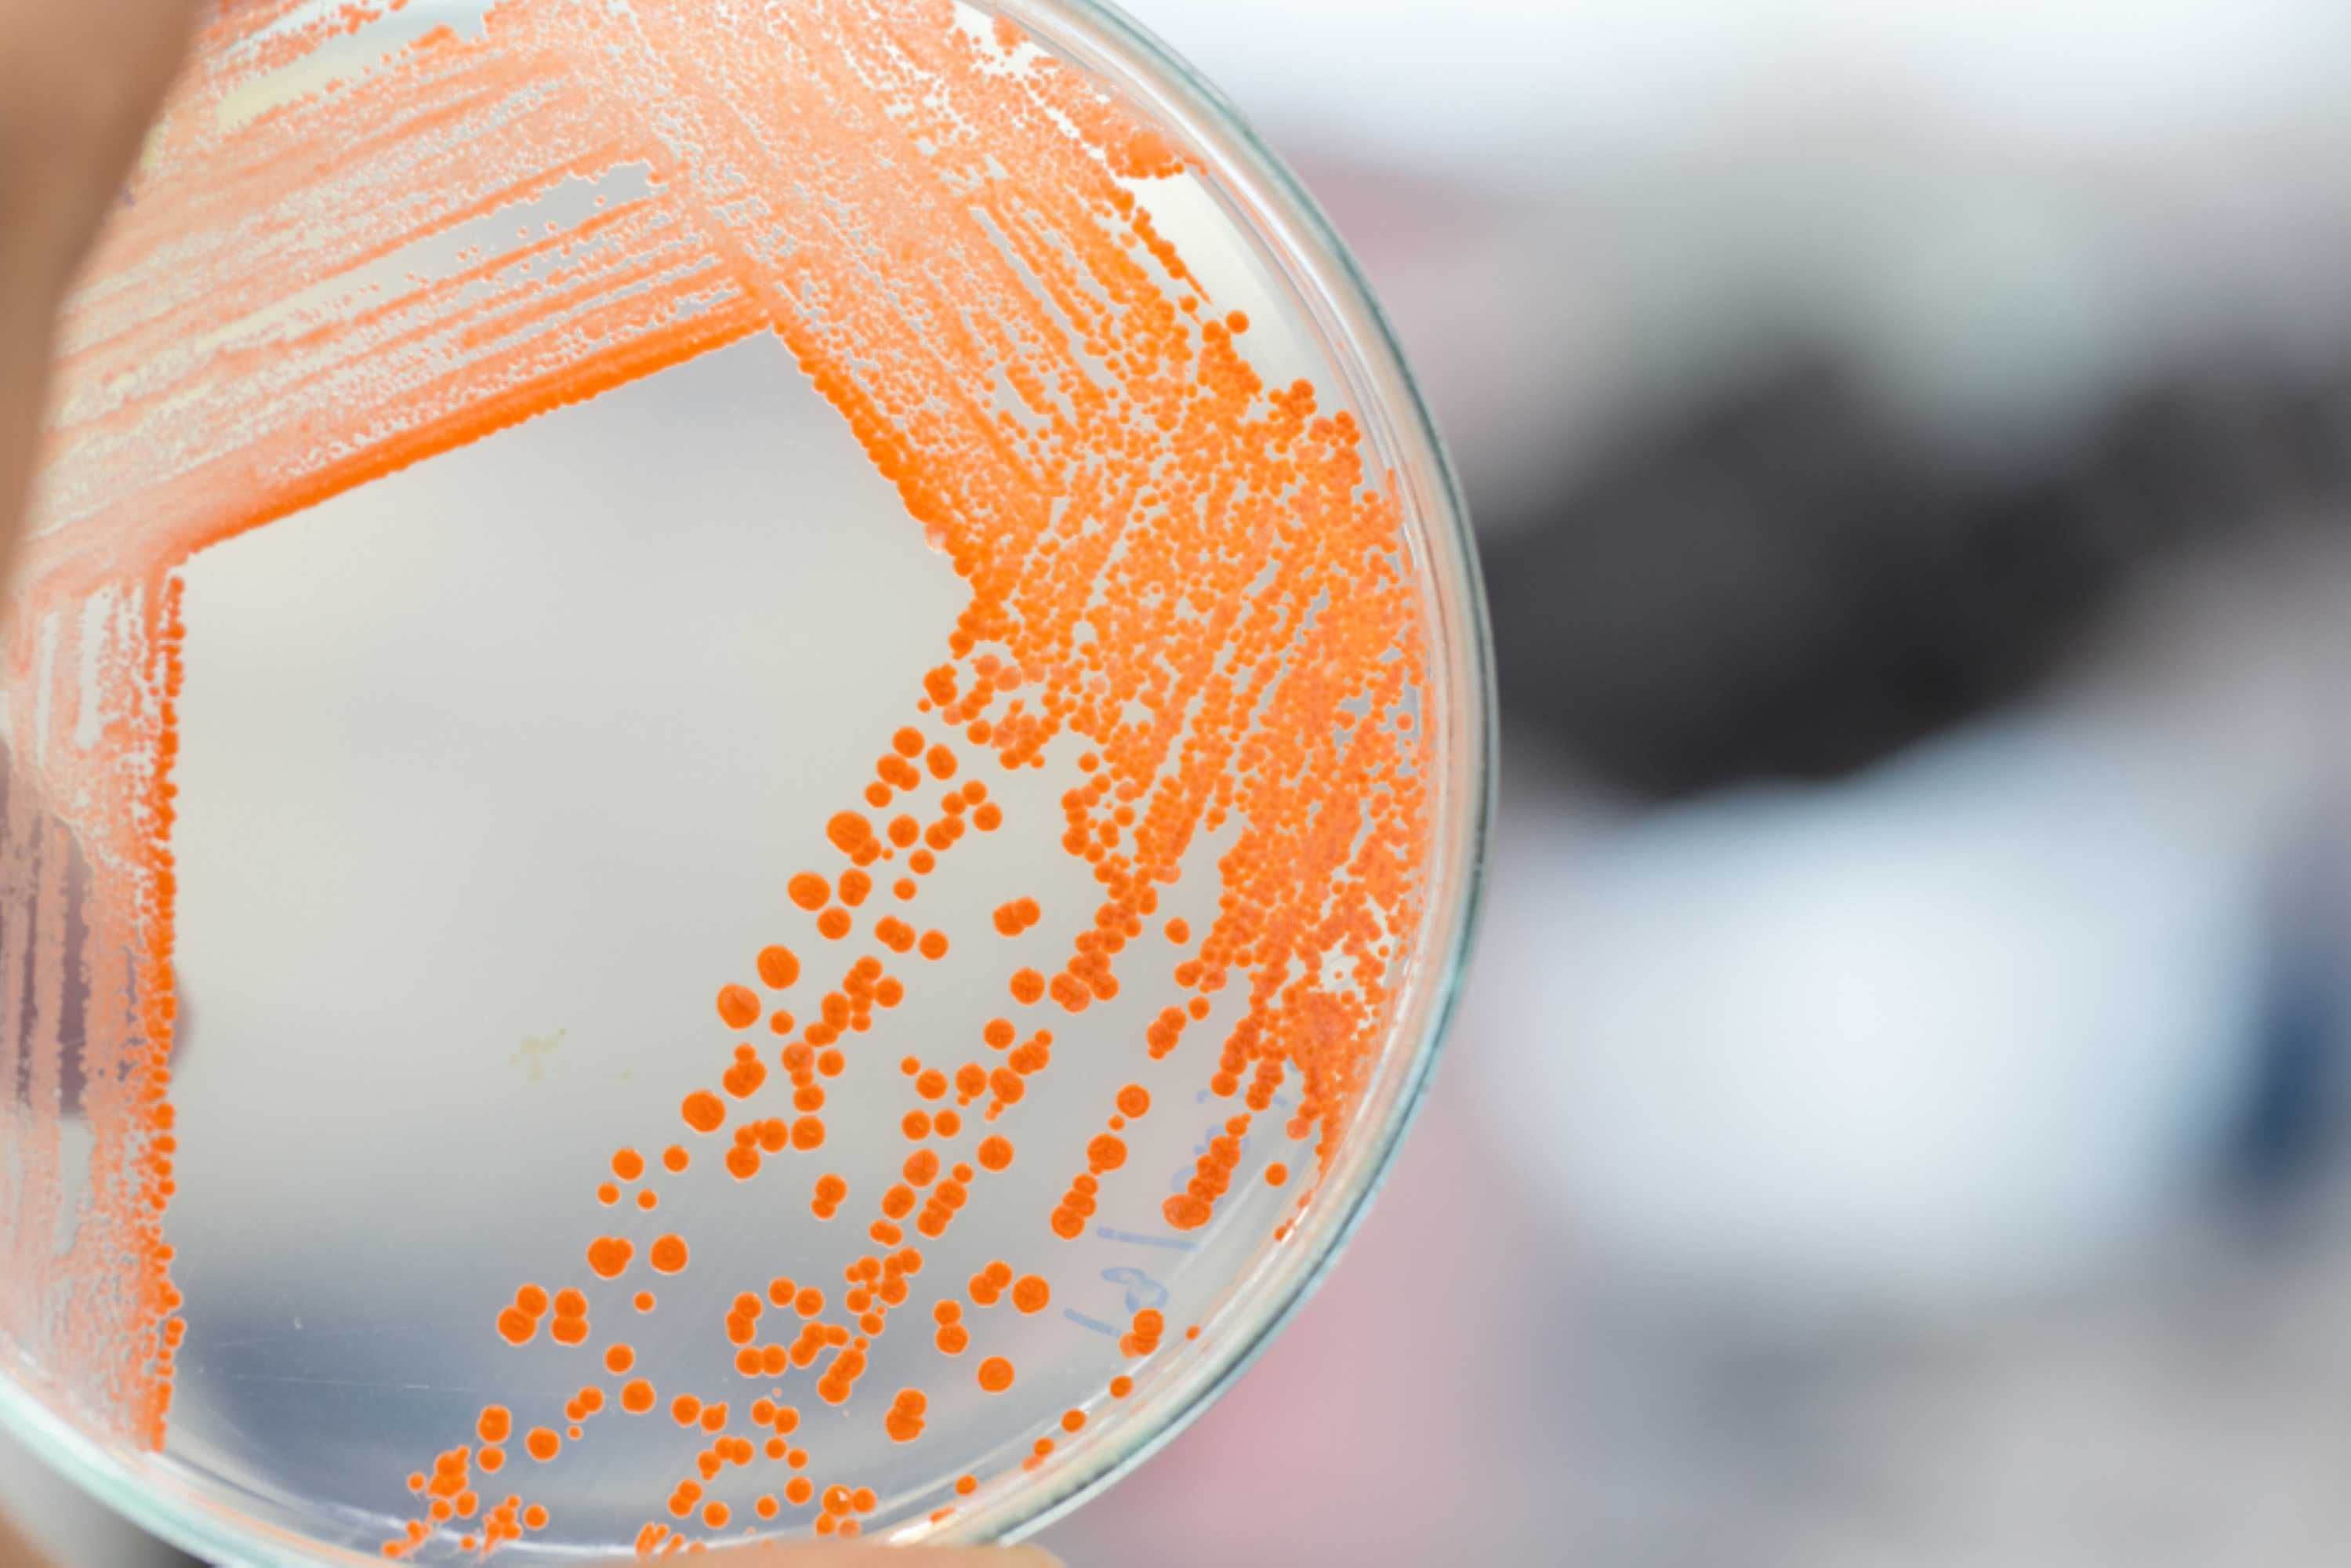
Remtech Space Operations

The REMTECH Space Technology Centre
Hungary's largest space MAIT (Manufacturing, Assembly, Integration and Testing) space technology centre is under construction. The REMTECH facility, capable of producing satellites up to 400 kilograms, will employ modular technology for efficient manufacturing, integration, and testing. This greenfield development builds on decades of heritage in space equipment design and MAIT and will significantly extend current capabilities while incorporating state-of-the-art technology solutions in line with global space industry standards.
Get in touch with Remred Space Technologies
Contact us for more information and custom solutions
REMTECH in numbers
Maximum Satellite Manufacturing Capacity
400 kg / 4 x 4 x 4 m³
Building Floor Area
4,000 m2
Clean Room Area
1,500 m2
Laboratory Area
650 m2
Office Area
750 m2
Topping out
April 2024
Foundation
May 2024
Construction
2024 Q2 – 2026 Q3
Operational Solutions
State-of-the-art, optimised, green energy-supported operational solutions
Facility type
Fully automated and modularly configurable ’New Space’ operation
Space Systems
MAIT Services
REMRED offers a wide range of space systems manufacturing, assembly, integration, and testing services, relying on the company’s almost 50 years of relevant heritage and in-house facilities.
Manufacturing, Assembly & Integration
REMRED Ltd. space systems production portfolio covers the first breadboard models and prototyping until flight model manufacturing under ECSS/IPC standards and all product assurance activities.


ECSS Electrical Assembly Training School
REMRED Ltd. develops an ECSS-compliant, ESA-certified electronics assembly training school.


Mechanical Manufacturing & Repair
REMRED Ltd. offers full service related to high-precision mechanical manufacturing and assembly including CNC milling, 3D printing, and Mechanical inspections.


Electrical Manufacturing & Repair
REMRED Ltd. offers full service for electronics and harness (flight) hardware manufacturing and assembly by certified staff according to ECSS/IPC requirements, including PCB procurements, Manual soldering, Automated soldering, PCBA repair/rework, Unit and module assemblies, Harness manufacturing, Wire wrapping, Cable crimping, Optical inspections, Conformal coating, and Unit and system-level board functional testing capabilities.


Space Systems Assembly & Integration
REMRED Ltd. offers ISO9 & ISO8 laboratories, ISO5 optical laboratories, and ISO8 integration halls for space systems procurement inspections, cleaning, preparation, permanent storage, assembly, integration, and all specific activities requiring clean environments.
Thermal-Vacuum Testing
REMRED Ltd. provides space system thermal-vacuum testing services in environmental testing laboratories and cleanrooms, complying with ECSS space industrial standards.


Climate Testing
Humidity testing, thermal cycling and thermal ambient testing in climate test chambers according to ECSS standards. Possibility of combination with vibration testing.


Overpressure Testing
Thermal cycling and thermal ambient testing in an overpressure vessel according to ECSS standards.


Thermal-Vacuum Testing
Thermal-vacuum (cycling) testing and thermal ambient testing (vacuum) in a thermal-vacuum chamber according to ECSS standards. Test Systems: ’KFKI’ Small TVAC Chamber, ’David’ Small TVAC Chamber, ’Goliath’ Large (55m3) TVAC Chamber.


Bakeout Testing
Vacuum and bakeout testing in thermal-vacuum bakeout chambers according to ECSS standards.
Mechanical Testing
REMRED Ltd. provides space system mechanical testing services in environmental testing laboratories and cleanrooms, complying with ECSS space industrial standards.


Vibration Testing
REMRED Ltd. offers vibration testing, including resonance search test, sine, and random vibration test, according to ECSS standards. It is possible to combine it with thermal vacuum testing. Test systems: ’KFKI’ Small (40kN) Shaker System, ’Hüperion’ Small (40kN) Shaker System, and’Titan’ Large (200kN) Shaker System.


Mechanical Properties Testing
REMRED Ltd. develops mechanical properties testing capability, including mass, CoG and Mol measurements, according to ECSS standards. Test systems: ’FLASH’ Large (400kg) Mechanical Properties Test System.


Schock Testing
REMRED Ltd. develops shock testing capability according to ECSS standards. Test systems: ’HULK’ Large (10,000g) Shock Test System.
Other Specific Testing
REMRED Ltd. provides space system-specific environmental testing services in applicable testing laboratories and cleanrooms, complying with ECSS space industrial standards.


EMC/EMI Testing
REMRED Ltd. offers EMC/EMI testing services in accordance with ECSS space industrial standards. Test systems: ’BAY ZOLTAN’ EMC test Chamber.

Microbial Testing
REMRED Ltd. offers microbial sampling and testing services in accordance with ECSS space industrial standards for contamination monitoring and control purposes


Acoustic Testing
REMRED Ltd. develops acoustic testing capability in accordance with ECSS standards, using the DEAT technology.
News.

REMRED Ltd.
29-33 Konkoly-Thege Miklos street
H-1121 Budapest,
Hungary




















